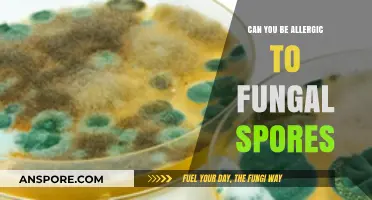
Understanding Fungal Allergies: Can You React to Fungal Spores?

The question of whether you can kill rice spores is a critical one, particularly in the context of food safety, agriculture, and storage. Rice spores, often associated with fungi like *Aspergillus* or *Fusarium*, can produce harmful mycotoxins that pose health risks if consumed. These spores are resilient and can survive under harsh conditions, including high temperatures and desiccation. While methods such as heat treatment, chemical fumigation, and irradiation can reduce spore viability, completely eradicating them is challenging. Understanding the limitations of these methods and implementing preventive measures, such as proper storage and moisture control, is essential to minimize spore contamination and ensure the safety of rice-based products.
| Characteristics | Values |
|---|---|
| Can Rice Spores Be Killed? | Yes, but with difficulty. Rice spores (likely referring to fungal spores like those from Fusarium or Magnaporthe oryzae) are highly resilient. |
| Effective Methods | Heat treatment (e.g., autoclaving at 121°C for 20-30 minutes), chemical disinfectants (e.g., bleach, hydrogen peroxide), and UV radiation. |
| Resistance to Desiccation | High; spores can survive in dry conditions for years. |
| Resistance to Heat | Moderate; requires high temperatures (above 100°C) for prolonged periods to kill. |
| Resistance to Chemicals | Variable; some spores are resistant to common disinfectants, requiring stronger or specialized chemicals. |
| Survival in Soil | Long-term; spores can persist in soil for multiple years, posing a risk to future crops. |
| Impact on Rice Cultivation | Significant; spore survival contributes to recurring fungal diseases like rice blast, affecting yield and quality. |
| Prevention Strategies | Crop rotation, resistant rice varieties, fungicides, and proper sanitation of equipment and fields. |
| Research Focus | Developing more effective fungicides, understanding spore dormancy mechanisms, and genetic resistance in rice varieties. |
Explore related products
$13.48 $14.13
What You'll Learn

Effectiveness of Heat Treatment
Heat treatment stands as a formidable adversary to rice spores, leveraging temperature to disrupt their cellular structures and render them inert. Studies indicate that exposing rice to temperatures of 120°C (248°F) for 15 minutes effectively eliminates spores of *Bacillus cereus*, a common contaminant. This method, known as dry heat sterilization, is particularly useful for pre-packaged rice products. However, it’s crucial to note that moisture content in raw or cooked rice can impede heat penetration, necessitating longer exposure times or higher temperatures for complete spore eradication.
For home cooks, achieving such precise conditions may seem daunting, but practical alternatives exist. Boiling rice at 100°C (212°F) for 10 minutes reduces spore viability significantly, though not entirely. To enhance effectiveness, consider pre-soaking rice in hot water (80°C or 176°F) for 30 minutes before cooking. This two-step approach mimics industrial processes, combining heat and moisture to weaken spore resistance. Always use a food thermometer to ensure temperature accuracy, as guesswork can lead to inconsistent results.
Comparatively, moist heat treatments, such as autoclaving at 121°C (250°F) for 15 minutes, are more efficient than dry heat methods due to steam’s superior penetration. This technique is ideal for large-scale food processing but impractical for household use. Instead, pressure cooking at 15 psi (121°C) for 10 minutes offers a viable home alternative, achieving similar spore destruction rates. However, overcooking can alter rice texture, so balance safety with culinary appeal.
A cautionary note: heat treatment is not a panacea. Spores in deeply contaminated rice may survive even extreme temperatures, especially if unevenly distributed. Always source rice from reputable suppliers and store it in airtight containers at temperatures below 15°C (59°F) to prevent spore germination. Combining heat treatment with proper storage practices maximizes safety, ensuring rice remains a wholesome staple in your diet.
Exploring the Presence and Role of Spores in Animal Biology
You may want to see also

Chemical Disinfectants for Spores
Rice spores, particularly those of fungi like *Aspergillus* or *Fusarium*, are notoriously resilient, surviving harsh conditions that would destroy most microorganisms. Chemical disinfectants offer a targeted approach to eradication, but not all are created equal. Quaternary ammonium compounds (QUATs), commonly used in household cleaners, are ineffective against spores due to their inability to penetrate the spore’s protective coat. Similarly, alcohol-based disinfectants, such as 70% isopropyl alcohol, fail to eliminate spores despite their efficacy against vegetative bacteria and viruses. These chemicals lack the oxidative or denaturing power required to breach the spore’s defenses, leaving them intact and viable.
For effective spore eradication, chlorine-based disinfectants emerge as a reliable option. Sodium hypochlorite (household bleach) at a concentration of 5,000–10,000 ppm (approximately 1:10 to 1:5 dilution of 5% bleach) can inactivate spores through oxidation, disrupting their cellular structures. However, prolonged exposure (30–60 minutes) is often necessary, and the corrosive nature of bleach limits its use to non-porous surfaces. Hydrogen peroxide, particularly in stabilized formulations like 7% solution, offers a safer alternative. Its oxidative action penetrates spore coats, achieving disinfection within 10–20 minutes, though efficacy depends on concentration and contact time.
Another potent option is peracetic acid, a broad-spectrum disinfectant effective against spores at concentrations as low as 0.2%. Its rapid action (5–10 minutes) and low environmental impact make it ideal for food processing and healthcare settings. However, its strong odor and potential skin irritation require careful handling. Glutaraldehyde, a 2% solution, is also effective but demands longer contact times (45–60 minutes) and poses health risks, limiting its practicality for routine use.
When applying chemical disinfectants, surface preparation is critical. Organic matter, such as soil or food debris, can shield spores from the disinfectant’s action. Pre-cleaning surfaces with detergent ensures maximum contact and efficacy. Additionally, temperature and pH influence performance; most chemicals work best at room temperature and neutral pH. Always follow manufacturer guidelines for dilution ratios and safety precautions, including wearing gloves and ensuring adequate ventilation.
In summary, while not all chemical disinfectants are spore-killers, chlorine-based agents, hydrogen peroxide, peracetic acid, and glutaraldehyde stand out for their efficacy. Each has unique strengths and limitations, requiring careful selection based on the application. Proper use, including correct concentration, contact time, and surface preparation, ensures successful spore eradication, safeguarding both food safety and public health.
Mushroom Spores and Allergies: Uncovering the Hidden Triggers and Symptoms
You may want to see also

Role of UV Light Exposure
UV light exposure has emerged as a promising method for killing rice spores, offering a chemical-free alternative to traditional sanitization techniques. Studies indicate that UV-C radiation, with wavelengths between 200 and 280 nanometers, is particularly effective at disrupting the DNA of spores, rendering them unable to germinate. For instance, a 2021 study published in *Food Microbiology* found that exposing rice spores to 10 mJ/cm² of UV-C light reduced their viability by 99.9%. This precision makes UV treatment a valuable tool in food processing and storage, where contamination by spores can lead to spoilage or health risks.
To implement UV light effectively, consider the following steps: first, ensure the UV-C source emits at the optimal wavelength range (254 nm is commonly used). Second, calculate the required dosage based on the spore load and surface area of the rice. For example, a 30-second exposure to a UV-C lamp with an intensity of 1 mW/cm² can deliver the necessary 10 mJ/cm². Third, maintain consistent exposure by using conveyor systems or rotating containers to ensure all surfaces receive uniform treatment. Practical tips include pre-cleaning rice to remove debris that might shield spores from UV light and monitoring lamp degradation, as UV intensity decreases over time.
While UV light is effective, it’s not without limitations. Spores in crevices or shaded areas may evade exposure, necessitating complementary methods like heat treatment. Additionally, UV-C light can degrade packaging materials like plastics, so it’s best suited for bulk processing or pre-packaging stages. Comparative analysis shows that UV treatment is faster and more eco-friendly than chemical sanitizers but requires careful calibration to avoid under-treatment. For small-scale applications, handheld UV-C devices are available, though industrial settings benefit from automated systems for consistency.
The persuasive case for UV light lies in its sustainability and safety. Unlike chemical treatments, UV leaves no residue and reduces the risk of antimicrobial resistance. It’s particularly appealing for organic rice production, where synthetic preservatives are prohibited. However, adoption requires investment in equipment and training, which may deter smaller producers. To maximize efficacy, combine UV treatment with humidity control, as dry conditions enhance spore susceptibility to UV damage. With proper implementation, UV light exposure stands as a reliable, modern solution for spore decontamination in rice.
Is Spore Available on Xbox? Exploring Compatibility and Gaming Options
You may want to see also
Explore related products

Survival in Different Environments
Rice spores, the dormant forms of fungi like *Fusarium* or *Aspergillus*, are remarkably resilient, surviving extreme conditions that would kill their active counterparts. Their survival hinges on their ability to withstand desiccation, temperature fluctuations, and chemical assaults. In environments ranging from arid deserts to humid tropics, these spores adapt by entering a cryptobiotic state, minimizing metabolic activity until conditions improve. This adaptability makes them a persistent threat to stored rice, where they can cause spoilage and produce mycotoxins harmful to humans and animals.
In humid environments, rice spores thrive due to the moisture that facilitates their germination and growth. To combat this, reduce humidity levels below 65% using dehumidifiers or proper ventilation. For stored rice, silica gel packets or desiccants can absorb excess moisture, creating an inhospitable environment for spore activation. Additionally, treating rice with 0.5% acetic acid (vinegar) for 10 minutes can inhibit spore germination without affecting grain quality, a method particularly useful in tropical regions.
Arid environments pose a different challenge, as spores can remain dormant for years, waiting for moisture to return. Here, the focus shifts to prevention. Store rice in airtight containers with oxygen absorbers, which create an anaerobic environment that stifles spore survival. Heat treatment is another effective method: exposing rice to 60°C (140°F) for 15 minutes kills most spores without damaging the grain. This technique is widely used in industrial settings but can also be adapted for small-scale storage using a conventional oven.
In cold environments, spores enter a state of suspended animation, surviving temperatures as low as -20°C (-4°F). Freezing rice for 72 hours can reduce spore viability, but it’s not foolproof. Combining freezing with other methods, such as gamma irradiation (at doses of 1-3 kGy), ensures near-complete spore eradication. However, this method is more practical for commercial operations due to the specialized equipment required. For home storage, focus on maintaining consistent low temperatures and minimizing moisture intrusion.
Finally, chemical treatments offer a versatile solution across environments. Sodium hypochlorite (bleach) at a concentration of 0.1% effectively kills spores on surfaces but is unsuitable for direct rice treatment due to its corrosive nature. Instead, fungicides like thiabendazole (0.1%) or propiconazole (0.05%) can be applied to grains, providing long-term protection. Always follow manufacturer guidelines and ensure treated rice is thoroughly washed before consumption. These methods, tailored to specific environments, ensure rice remains safe and spore-free, safeguarding both food security and health.
Equinox's Abilities: Can They Proc Saryn's Spores in Warframe?
You may want to see also

Prevention Methods in Storage Areas
Rice spores, particularly those of fungi like *Aspergillus* and *Fusarium*, are remarkably resilient and can survive harsh conditions, including desiccation and extreme temperatures. Once established, they are nearly impossible to eradicate without damaging the rice itself. Therefore, prevention in storage areas is not just beneficial—it’s critical. The key lies in controlling the environment to make it inhospitable for spore germination and growth.
Step 1: Maintain Optimal Temperature and Humidity
Spores thrive in warm, humid conditions. Store rice in a cool, dry environment, ideally at temperatures below 15°C (59°F) and humidity levels under 14%. Use dehumidifiers or silica gel packets to absorb excess moisture, especially in tropical climates. Regularly monitor conditions with a hygrometer to ensure consistency. For large-scale storage, consider air conditioning or ventilation systems to regulate airflow and prevent condensation, which can activate dormant spores.
Step 2: Ensure Proper Packaging and Sealing
Air and moisture are the enemies of spore-free storage. Use airtight containers made of food-grade plastic, glass, or metal. Vacuum-sealed bags are particularly effective, as they eliminate oxygen, which spores need to grow. For bulk storage, invest in hermetically sealed silos or bins with gasketed lids. Inspect packaging for cracks or leaks before use, and replace damaged containers immediately.
Step 3: Implement Sanitation Protocols
Spores can hitchhike on dust, pests, or even human clothing. Clean storage areas thoroughly before introducing new rice batches. Use a HEPA-filtered vacuum to remove dust and debris, followed by a wipe-down with a food-safe disinfectant. Avoid chemical treatments that may leave residues; instead, opt for steam cleaning or natural sanitizers like vinegar solutions. Regularly inspect for pests like weevils, which can carry spores, and use traps or diatomaceous earth as preventive measures.
Caution: Avoid Cross-Contamination
Spores can spread easily between batches. Never store new rice with older stock without proper inspection. Quarantine suspicious batches and test for mold growth using rapid test kits (e.g., lateral flow devices for aflatoxin detection). If contamination is detected, discard the affected rice and clean the storage area before reintroducing fresh stock. Rotate stock using the FIFO (First In, First Out) method to minimize the risk of prolonged storage, which increases spore activation.
Killing rice spores post-contamination is nearly impossible, but prevention is straightforward and cost-effective. By controlling temperature, humidity, packaging, and sanitation, you create an environment where spores cannot thrive. These methods not only protect rice quality but also safeguard health by preventing mycotoxin production. In storage, vigilance is your greatest ally—small, consistent efforts yield long-term preservation.
Pulsed Xenon UV Light: Effective Against C. Diff Spores?
You may want to see also
Frequently asked questions
Yes, rice spores can be killed through methods such as heat treatment, chemical disinfection, or exposure to ultraviolet (UV) light.
Rice spores are typically destroyed at temperatures above 121°C (250°F) for at least 15 minutes, such as through autoclaving or boiling.
Yes, bleach (sodium hypochlorite) can effectively kill rice spores when used at appropriate concentrations, usually 5-10% solution, with sufficient contact time.
Rice spores can survive in dry conditions for extended periods, but they are more susceptible to desiccation over time, especially in low-humidity environments.